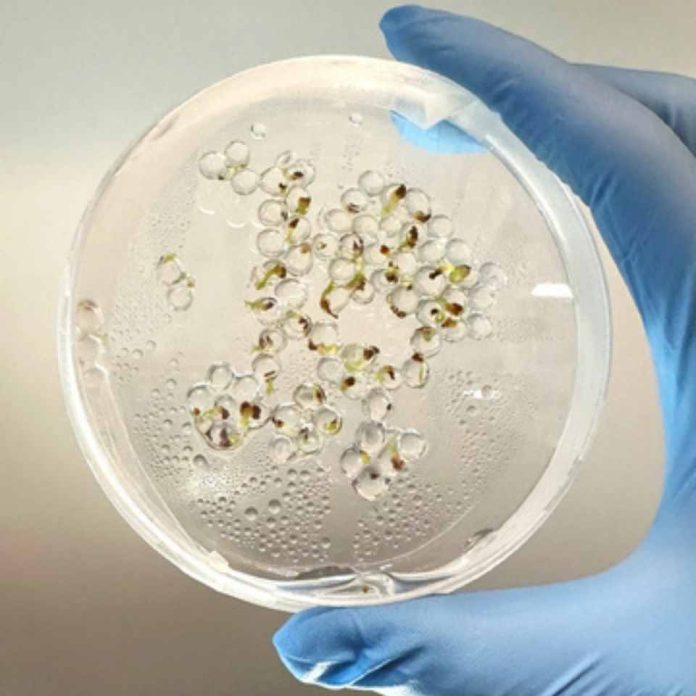
Foray Bioscience anuncia su primera asociación de semillas fabricadas con West Coast Chestnut Foray Bioscience anuncia su primera asociación de semillas fabricadas con West Coast Chestnut

CAMBRIDGE, Massachusetts–( BUSINESS WIRE ) Foray Bioscience , empresa de bio fabricación de plantas que cultiva productos vegetales desde la célula, anunció hoy su primera colaboración en el sector de las semillas con West Coast Chestnut , un vivero líder en cultivo de castaños mediante cultivo de tejidos. Esta colaboración surge tras la validación de los productos de «semillas fabricadas» de Foray, que permiten la propagación escalable a partir de células individuales, acelerando así la comercialización de nuevas variedades vegetales. Las semillas fabricadas son embriones vegetales encapsulados, cultivados directamente a partir de células vegetales, que pueden sembrarse como una semilla convencional para producir una planta completa.
Este anuncio marca la primera colaboración de Foray para la comercialización de semillas fabricadas y subraya la creciente demanda de tecnologías de propagación acelerada de plantas. En virtud del acuerdo, Foray desarrollará semillas fabricadas para variedades selectas de castaño, con el objetivo de reducir el tiempo de comercialización mediante un rápido crecimiento y pasos de aclimatación abreviados que dificultan la propagación tradicional. El acuerdo describe un contrato plurianual de compra a plazos de semillas fabricadas de cultivares de castaño de importancia regional. También establece a West Coast Chestnut como socio clave en la validación de productos adicionales de semillas fabricadas para la reforestación en el Pacífico Noroeste.
“Nos entusiasma trabajar con Foray para explorar una nueva forma de ampliar la propagación del castaño”, afirmó Sawyer Clark, de West Coast Chestnut. “Llevamos años trabajando con diversas variedades de castaño en cultivo de tejidos y cultivando para que estén listas para los productores. Sin embargo, el proceso de propagación de cada variedad es lento y requiere una inversión considerable. Las semillas fabricadas tienen el potencial de abrir una nueva vía de propagación más rápida, predecible y escalable”.
West Coast Chestnut aporta experiencia en propagación de cultivos de tejidos, desarrollo de huertos y cultivo de árboles, lo que convierte a la organización en un socio temprano bien posicionado para probar la tecnología de semillas fabricadas de Foray.
“Este trabajo representa un cambio en la forma de escalar las plantas”, afirmó la Dra. Ashley Beckwith, fundadora y directora ejecutiva de Foray Bioscience. “Al combinar el cultivo de células vegetales, la experimentación dirigida por IA y la tecnología de semillas fabricadas en una sola plataforma, estamos convirtiendo la propagación en un proceso predecible y repetible. Este enfoque está diseñado para garantizar un suministro confiable para muchas especies de plantas donde la consistencia y la escala han sido históricamente inalcanzables”.
El contrato se basa en la estrategia de plataforma más amplia de Foray, que combina las capacidades de bio producción física con Pando, su software de I+D basado en IA . Juntos, estos sistemas permiten a Foray desarrollar, optimizar y reproducir sistemáticamente los procesos de crecimiento vegetal en diversas especies y casos de uso.
Acerca de Foray Bioscience
Foray permite crear cualquier producto vegetal a partir de una sola célula. Mediante el cultivo de células vegetales, herramientas de I+D basadas en IA y sistemas de producción escalables, Foray permite controlar el crecimiento de las plantas desde una sola célula. La empresa colabora con los sectores forestal, agrícola y de productos naturales para crear un acceso duradero a las plantas y sus productos, redefiniendo nuestra forma de cultivar.
Acerca de West Coast Chestnut
West Coast Chestnut es una granja y vivero de castaños de propiedad familiar, ubicado en el valle de Willamette, Oregón, con más de 30 años de experiencia en el cultivo de plantas perennes, como castañas, avellanas y arándanos. La empresa se centra en la propagación de castaños para la producción comercial, la agricultura regenerativa y la restauración del hábitat.